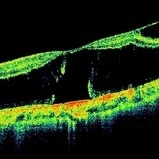

-
Uveitis With Exudative Retinal Detachment
May 3 2014 by Mallika Goyal, MD
Fluorescein angiogram of an elderly patient with bilateral posterior uveitis shows punctate hyperfluorescence and inferior RD. He responded well to oral steroids with complete resolution of the uveitis and RD.
Photographer: Mallika Goyal, MD, Apollo Health City, Jubilee Hills, Hyderabad, India
Condition/keywords: exudative retinal detachment, uveitis
-
Uveitis With Exudative Retinal Detachment
May 3 2014 by Mallika Goyal, MD
Fluorescein angiogram of an elderly patient with bilateral posterior uveitis shows punctate hyperfluorescence and inferior RD. He responded well to oral steroids with complete resolution of the uveitis and RD.
Photographer: Mallika Goyal, MD, Apollo Health City, Jubilee Hills, Hyderabad, India
Condition/keywords: exudative retinal detachment, uveitis
-
Hereditary Dominant Drusen
Nov 16 2015 by Mallika Goyal, MD
Bilateral hereditary dominant drusen in a young healthy male. No visual symptoms, macula healthy.
Photographer: Mallika Goyal, MD
Condition/keywords: drusen
-
Bilateral Myopic Foveoschisis
Bilateral Myopic Foveoschisis
Feb 11 2016 by Mallika Goyal, MD
Left eye OCT of a 22-year-old lady with myopic foveoschisis & an outer lamellar macular hole who presented with complaint of Left Eye vision drop 4 months prior to presentation. BCVA was 20/400. The lamellar macular hole accounts for the vision loss.
Condition/keywords: myopic foveoschisis

A project from the American Society of Retina Specialists